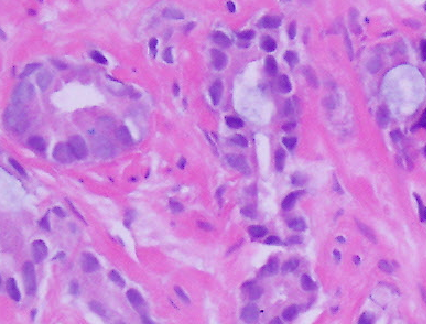

You are looking at the headline and thinking, “Boy, this guy has lost it. He doesn’t even know that 3+3=6.” Well, that’s the way it used to be in prostate cancer. But in the last year or so, the assembled multitude of prostate pathologists have gotten a lot smarter, or at least more sensible. The benefit is to the patient, making the choices that have to be made in dealing with prostate cancer a little more straightforward.
You see, whenever we are looking at a slide in a case of cancer, one of the pathologist’s most important jobs is trying to estimate, based on the tumor’s microscopic appearance, how aggressive it might be. Often, we use generalized terms, identifying the cancer as “well-differentiated,” or “poorly-differentiated,” or for those somewhere in between, the highly nebulous term “moderately-differentiated.” Sometimes we use the phrases “low grade” and “high grade.” In breast cancer, we may use numeric scores for various microscopic features, add them all up and come up with a score to pass on to the oncologist and patient.
And then there is prostate cancer, home of the Gleason Grade and Score. The Gleason Grade is named for Donald Gleason, a pathologist whom back in the 1960’s examined tons of prostatectomy (removal of the prostate) specimens at the Minneapolis Veterans Administration Medical Center and recognized various microscopic patterns that he connected to different degrees of aggressiveness. He gave these patterns a numeric value of 1 through 5, creating the Gleason Grade. The Gleason Score was obtained by adding together the 2 most common grades, and thus could range from 2 (least aggressive) to 10 (most aggressive.) And there the matter stood, with minor adjustments by panels of renowned pathologists, for almost 50 years.
So what’s wrong with the Gleason system? The problem is twofold. First, Gleason Grades 1 and 2 were sort of wishy-washy tumors that might not have acted much like cancer at all. Second, Gleason’s studies were all done with the entire prostate available, while now, most patients are diagnosed with skinny needle biopsies that don’t even reach the center portion of the prostate gland where most of Gleason’s Grades 1 and 2’s could be found. Also, these skinny needles biopsies aren’t large enough to show the architectural patterns needed for the diagnosis of those 1’s and 2’s.
What’s the upshot, and why is any of this important? Based on the paragraph above, you can see that the least aggressive prostate cancer that we are going to diagnose on a needle biopsy is a Gleason Grade of 3+3 for a Gleason Score of 6. And we now know that for many men with a Gleason Score of 6, an approach called “active surveillance,” which means careful follow-up without definitive therapy, may now be the treatment of choice. Do you see where the problem is going to be?
Mr. Jones has a prostate biopsy for an elevated PSA and I diagnose prostate cancer Gleason Grade 3+3=6. Dr. Smith tells Mr. Jones “You have cancer, but I think that rather than surgery or radiation, we can try active surveillance.” But Mr. Jones has been doing his Googling and says “But Dr. Smith! My cancer is a 6 out of 10, and I think that is pretty bad! I want treatment.”
Thus the dilemma, a cancer that sounds much more aggressive than it may truly be. To resolve this discrepancy, we have a new approach. We still determine a Gleason Score, but we now additionally place the tumors in Groups 1 through 5. The higher the Gleason Score the higher the Group. Our old lackadaisical but scary Gleason Score 3+3=6 is all alone in Group 1. Gleason Score 3+4=7 earns a Group 2, 4+3=7 occupies Group 3, and the various higher Gleason Scores comprise Groups 4 and 5.
Now Dr. Smith can say, “Mr. Jones, you have prostate cancer Group 1 and I think we can hold off on any treatment for now.” And it is a whole lot easier for Mr. Smith to respond, “I think that is a fine idea.”
All it took was some modern math.
_______
The opinions above are those of the author and not of UroPartners LLC.
_______
_______
Like what you read here? Add your name to our subscription list below. No spam, I promise!
___
#mc_embed_signup{background:#fff; clear:left; font:14px Helvetica,Arial,sans-serif; }
/* Add your own MailChimp form style overrides in your site stylesheet or in this style block.
We recommend moving this block and the preceding CSS link to the HEAD of your HTML file. */
Subscribe to our mailing list
//s3.amazonaws.com/downloads.mailchimp.com/js/mc-validate.js(function($) {window.fnames = new Array(); window.ftypes = new Array();fnames[0]=’EMAIL’;ftypes[0]=’email’;fnames[1]=’FNAME’;ftypes[1]=’text’;fnames[2]=’LNAME’;ftypes[2]=’text’;}(jQuery));var $mcj = jQuery.noConflict(true);